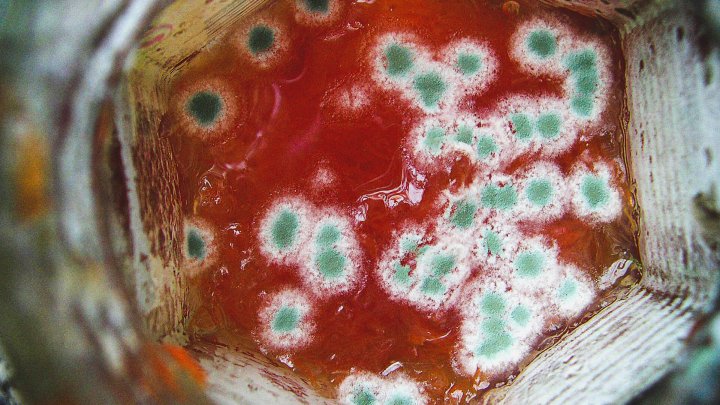
Gıda Zehirlenmeleri Nasıl Önlenir?

IPES-Gıda Uzmanı Jennifer Clapp gıda güvensizliğini ve mevcut gıda sisteminin yarattıklarını anlatıyor.

Yetersiz denetim, ekonomik kaygılar, mevzuat açıkları birleşince gıda zehirlenmeleri riskini artırıyor. Bunun faturası da oldukça yüksek oluyor.
Gıda bilimi temelde gıda zehirlenmelerine neden olan etkenlerin ortadan kaldırılmasını sağlayarak insanların güvenilir gıdalara ulaşmasını amaçlar. Bu amaca ulaşılamadığında sağlık sistemi üzerinde büyük bir yük ortaya çıkar ve insanların güvenilir gıdaya erişim hakkı da ihlal edilmiş olur. Peki gıda zehirlenmeleri neden artıyor?
Tarım ve Orman Bakanlığı tarafından 2021 yılında kayıt/onay kapsamında 704.588 gıda işletmesi olduğu kamuya açıklandı. Bu sayı son 2019’dan bugüne %4.4 artış göstermiş. Bu işletmelerin 81.904'ü üretim, 344.759'u satış ve 277.925'i toplu tüketim yerleri olarak beyan edilmiş. Mevcut gıda mevzuatına göre 10 kişiden fazla personel veya 30 beygirden fazla motor gücüne sahip gıda işletmelerinin İstihdamı Zorunlu Personel çalıştırma zorunluluğu bulunuyor. Belirlenen bazı üretim alanlarında faaliyet gösteren gıda işletmelerinin de bu koşula bağlı olmadan İstihdamı Zorunlu Personel çalıştırma zorunluluğu bulunuyor.
Gıda İşletmelerinin yaklaşık %80’i küçük ve orta birimde işletmelerden oluşuyor. Bu da gıda işletmelerinin büyük bir kısmında İstihdamı Zorunlu Personel çalışmaması ve üretimin denetlenmemesi anlamına geliyor. Öte yandan mevzuatın içerisinde büyük bir açık daha bulunuyor. Gıda işletmelerinde İstihdamı Zorunlu Personel olarak çalışabilecek meslek unvanları tutarsız olarak belirlenmiş durumda. Gıda ışınlama üzerine faaliyet gösteren bir işletme su ürünleri mühendisi, unlu mamul üreten bir fırın kimyager, hazır yemek üreten bir kurum ev ekonomistini İstihdamı Zorunlu Personel olarak çalıştırabiliyor. Gıda işletmelerine göre uzmanlığı bulunmayan meslek gruplarının İstihdamı Zorunlu personel olarak belirlenmesi gıda güvenliğini tehlikeye atıyor ve gıda zehirlenmelerine yol açabiliyor.
Tarım ve Orman Bakanlığı’nda 2019 yılında 19.917 mühendis ve 7.200 veteriner hekim görev yapmış. Personel sayısı 3 yıl içerisinde %3 azalarak 2021 yılında 19.231 mühendis ve 7.001 veteriner hekime gerilemiş. Buna karşılık gıda denetimleri de son 3 yılda 1.215.996’dan 1.378.185’e yükselmiştir. Denetimlerde görev yapan personel sayısı da son 3 yılda 7.004’ten 7.245’e yükselmiştir. Bu veriler Bakanlık kadrolarının küçülmeye gittiğini ve önceden idari görevde bulunan personellerin gıda kontrol ekiplerinde görev yapmaya başladığını göstermektedir. Bir yılda gerçekleştirilen denetim sayılarına bakıldığında denetimde geçirilen sürenin daha da azaldığı ve daha az noktaya dikkat edildiği de verilerle anlaşılmaktadır.
Ekonomik kaygılar gıda güvenliği üzerinde büyük risk oluşturuyor. Elektrik fiyatlarının yükselmesiyle beraber tüketimi düşürmek için gıda satış noktalarında buzdolaplarının devreden çıkarıldığı görülüyor. Ürünler bir dolabın içerisine ambalaj hasarı önemsenmeden tıka basa yerleştiriliyor ve birkaç dolap devreden çıkartılıyor. Bu durum doldurulan dolapların soğutma performansını önemli ölçüde azaltıyor ve ürünlerin sıcaklığının artmasına sebep oluyor. Ayrıca ambalaj hasarıyla risk daha da artıyor. Akaryakıt fiyatlarının artmasıyla lojistik aşamasında frigorifik araçların soğutucuları kapatılabiliyor ve soğuk zincir lojistik aşamasında da kırılıyor. Su fiyatlarının artmasıyla hammaddenin yıkanma, durulanma gibi aşamaları yetersiz suyla gerçekleştirilebiliyor.
Üzerine Ar-Ge çalışması gerçekleştirilen, bir üretim hattı ve kapasitesi bulunan ürünlerde gramajların azaltıldığı gözlenmektedir. Bu ürünlerin hammaddelerinin büyük bir kısmında dışa bağımlı konumda bulunuyoruz. Bu durum ürünlerin fiyatlarının artışını etkilemektedir. Üründeki olası bir hammadde değişimi ek olarak bir Ar-Ge yatırımı daha gerektirmektedir. Bunun sonucunda tüketime bağlı olarak üretim kapasitesinin ciddi oranda düşme riski bulunmaktadır. Bunun yerine gıda işletmeleri gıda güvenliğini sağlayan departmanlarında kesintiye gitmektedir. Bu kesintiyle beraber personel sayısı, teknik harcamalar, analiz ve kalibrasyon maliyetleri düşürülmektedir. Bu da çeşitli gıda güvenliği risklerine yol açarak gıda zehirlenmelerine neden olabilmektedir.
Toplu tüketim ve hazır yemeklerde üretimin, gıda güvenliğini sağlamanın ve personelin optimal bir maliyeti bulunuyor. Ekonomik kaygılar ve maliyetlerden ötürü bu maliyetin altına sıklıkla inildiği gözlemleniyor. Bu durum da hammaddelerin daha ucuz hammaddelerle değiştirilmesine, gıda güvenliği için ayrılan teknik harcamaların ve personel sayısının azaltılmasına yol açıyor. Böylece yine gıda güvenliği riskleri ortaya çıkarak bu sefer toplu gıda zehirlenmeleri yaşanmasına sebep oluyor.
2015-2020 yılları arasında sağlık kurumlarına gıda zehirlenmesi nedeniyle 11.384.479 kişi tarafından 18.314.239 başvuru gerçekleştirilmiş. Yine aynı tarihler arasında 1.714 kişi gıda zehirlenmesi nedeniyle hayatını kaybetmiş. Bu istatistiğin de doğru olduğunu söylenemez. Çünkü gıda zehirlenmesi şikayetiyle hastaneye başvuran hastaların şikayetleri sıklıkla farklı tanı kodları adı altında değerlendirilebiliyor. Böyle bir durumda kayıtlarda zehirlenme geçmediği için zehirlenen kişinin yediği gıdalardan numune alınmıyor.
Elde edilebilen tek veriye göre gıda zehirlenmesi geçiren her kişinin aynı asgari tedaviyi gördüğü varsayılırsa bunun sağlık sistemine etkisi yaklaşık 2 Milyar Lira olarak hesaplanmaktadır.
Bu durumların neticesinde şöyle bir tabloyla karşılaşıyoruz. Birleşmiş Milletler’in açıkladığı verilere göre Türkiye’de 14,8 milyon insan yetersiz ve güvensiz gıdalarla besleniyor. Bu rakam yaklaşık olarak ülkemizin nüfusunun %17’sine karşılık geliyor. Son 3 ayda 410 bin, son 1 ayda 60 bin kişi eklenmiş bu istatistiğe ve bu durum hızlı bir biçimde artış gösteriyor. 5 yaş altı çocuklarımızın %6’sı kronik, %1,7’si ağır şekilde yetersiz ve güvensiz gıdalarla besleniyor.
Avrupa Birliği ve Amerika Birleşik Devletleri’ne bakıldığında gıda zehirlenmeleriyle ilgili veriler şeffaf bir şekilde dijital olarak kamuyla paylaşılmaktadır. Amerika Birleşik Devletleri’nde 2009-2020 yılları arasında 168.656 gıda zehirlenmesi vakası bildirildiği, bunlardan 9.720’sinin toplu zehirlenme vakası olduğu, 10.983 kişinin hastanede tedavi gördüğü ve 268 kişinin gıda zehirlenmesi nedeniyle hayatını kaybettiği açıklanmıştır. Avrupa Birliği’deyse 2020 yılında 3.143 gıda zehirlenmesi vakası bildirilmiş ve 48 kişinin gıda zehirlenmesi nedeniyle hayatını kaybettiği açıklanmıştır.
• Tarım ve Orman Bakanlığı yapısı Gıda Bakanlığı, Kooperatif ve Kalkınma Bakanlığı, Toprak ve Tarım Bakanlığı olarak üçe ayrılmalı
• TMMOB, TVHB, TTB, akademisyenler ve ilgili bakanlık temsilcilerinin yer aldığı bilimsel ve bağımsız Ulusal Gıda Güvenliği Kurumu kurulmalı
• Gıda güvenliğini ekonomik baskılardan kurtaracak yasal düzenlemeler gerçekleştirilmeli
• Gıda ürünleri QR kod vasıtasıyla kimliklendirilmeli
• Gıda lojistiğinin başladığı araçlardan satış noktalarında muhafaza edildiği alanlara kadar Blockchain İzlenebilirlik Sistemi ile soğuk zincir, depolama koşulları ve üründeki değişimlerde izlenebilirlik sağlanmalı
• Kayıt dışı gıda işletmeleri tek tek denetlenmeli ve ulusal standartları sağlamayan işletmeler faaliyetten men edilmeli
AGPAM’ın sizin için önerdiği çalışmaları okuyun.
AGPAM’ın çalışma alanlarını ve gerçekleştirdiği çalışmaları inceleyin.